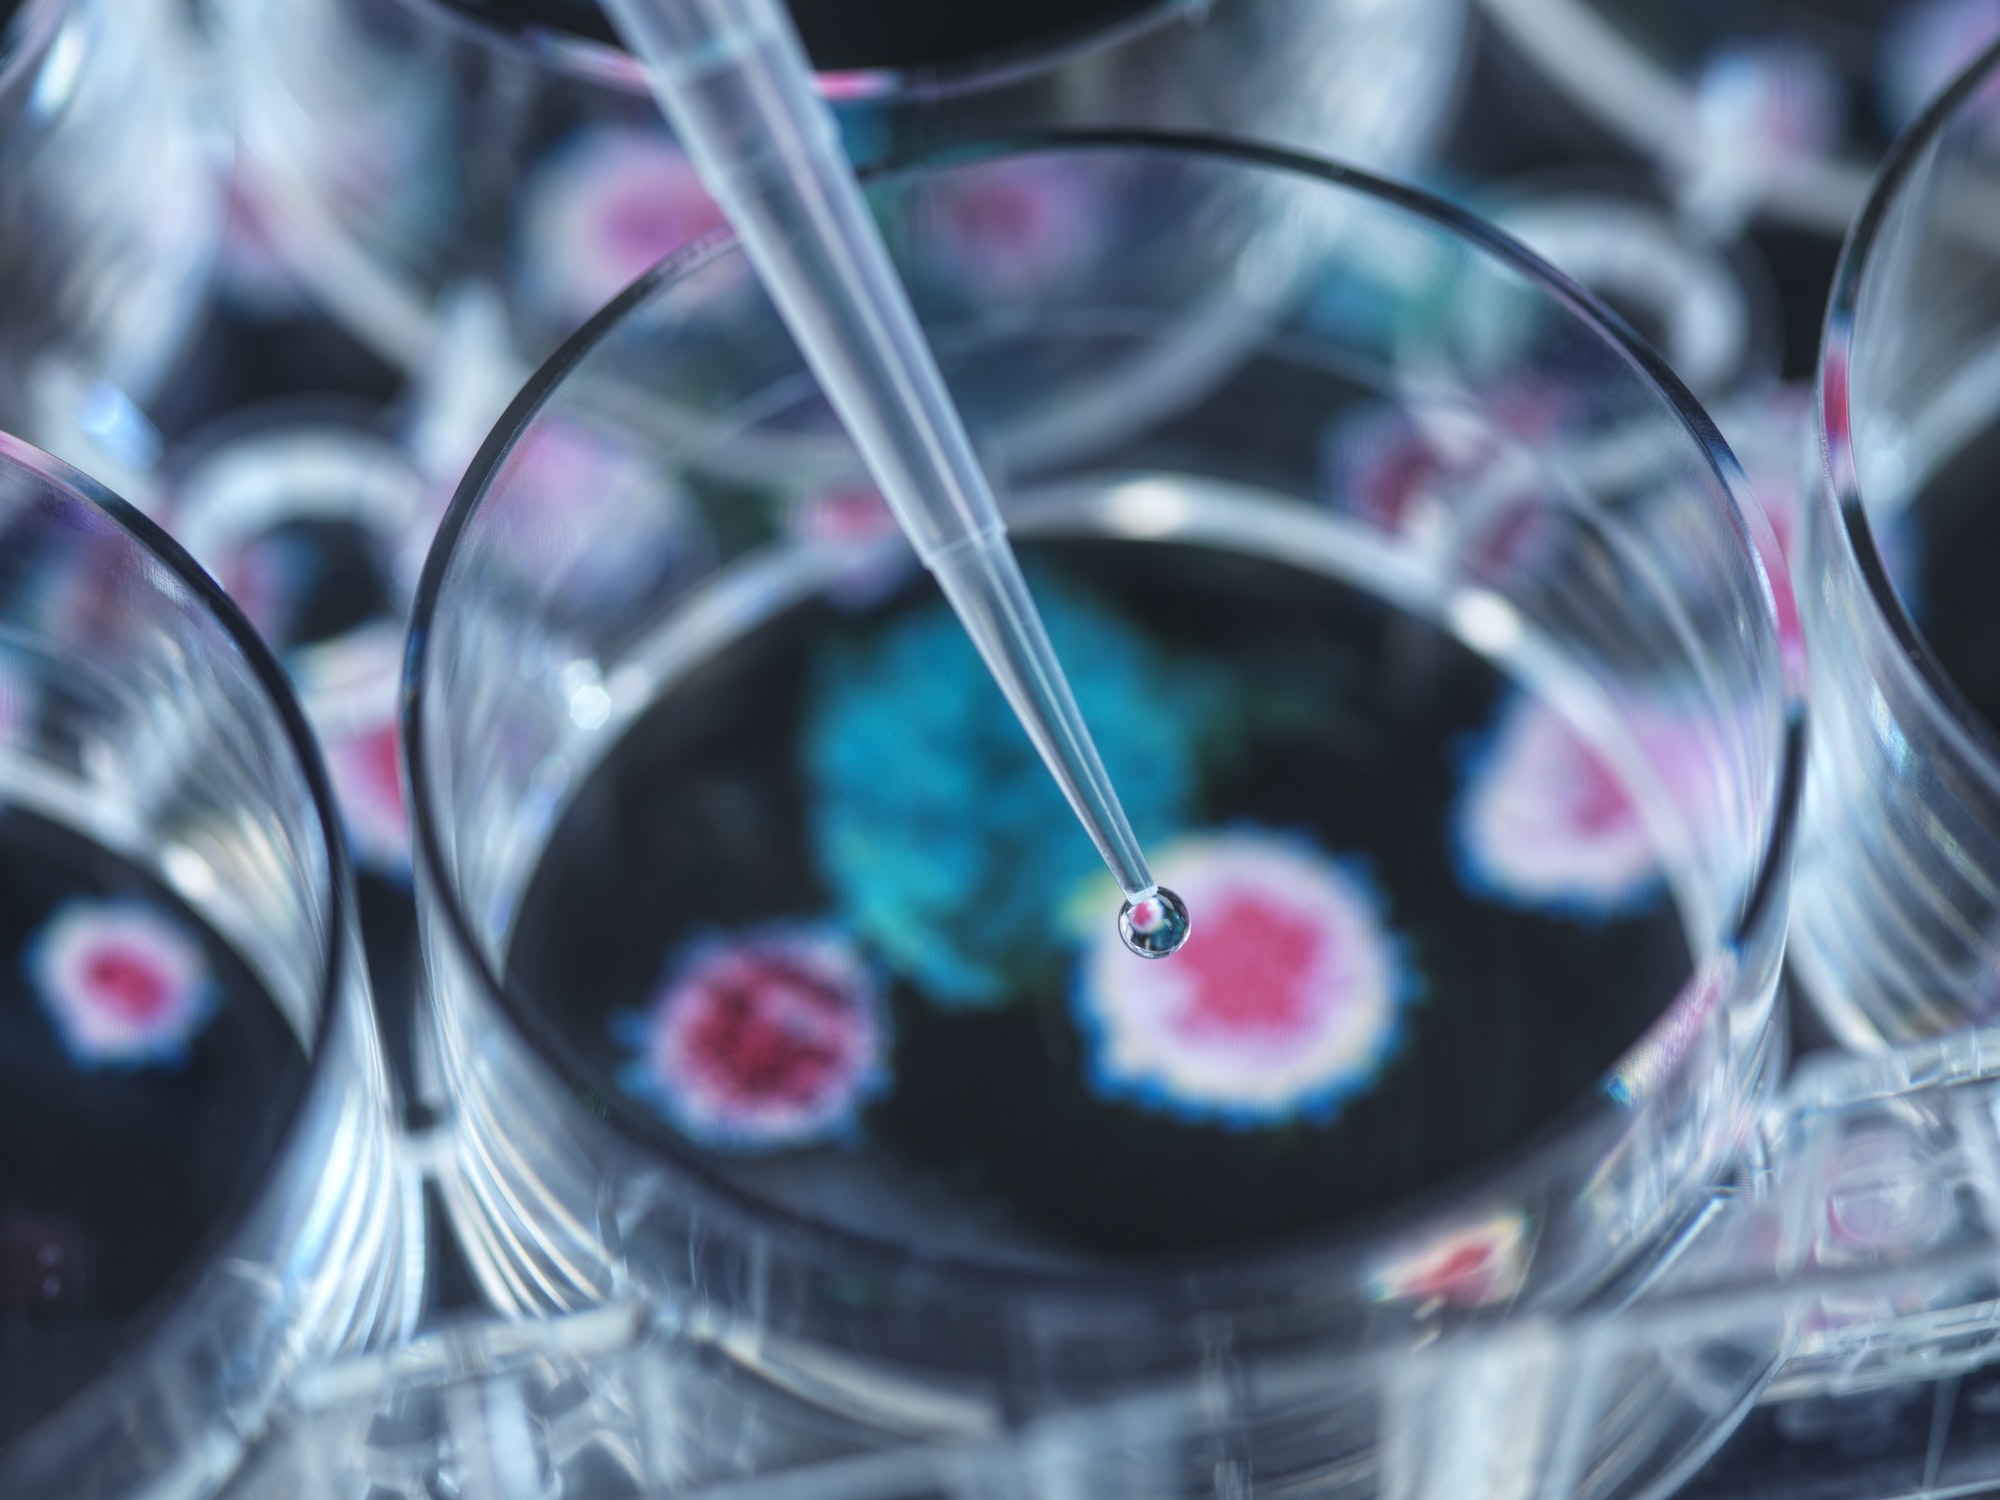

En una nueva edición de El Mostrador en La Clave, Macarena Fernández y Francisca Castillo conversaron en primera instancia con la vicepresidenta ejecutiva de la Federación de Empresas de Turismo (FEDETUR), Helen Kouyoumdjian, sobre la flexibilización respecto a la homologación de las vacunas de turistas internacionales para fomentar el turismo en el país, sin embargo, se espera una baja de un 25% de visitantes del exterior. En el segundo bloque, el abogado constitucionalista y coordinador del Observatorio Nueva Constitución, Tomás Jordan, analizó las últimas novedades de la Convención Constituyente como el fin del Senado para el 2026, el quórum de 4/7 para cambios constitucionales en caso de ganar el Apruebo y la incertidumbre sobre posibles invitaciones a los expresidentes a la ceremonia de cierre de la Convención. Posteriormente, el infectólogo, pediatra y profesor de la Facultad de Medicina de la Universidad de Chile, Miguel O’Ryan, se refirió a la medida del gobierno de adelantar las vacaciones de invierno a los estudiantes ante el importante alza de enfermedades respiratorias en menores. Por último, el director ejecutivo del Centro de Humedales Río Cruces de la Universidad Austral, Ignacio Rodríguez, habló sobre la preocupante baja de población de cisnes de cuello negro en Valdivia.
La vicepresidenta ejecutiva de la Federación de Empresas de Turismo (FEDETUR), Helen Kouyoumdjian, habló sobre la flexibilización respecto a la homologación de las vacunas de turistas internacionales para fomentar el turismo en el país, sin embargo, se espera una baja de un 25% de visitantes del exterior.
El infectólogo, pediatra y profesor de la Facultad de Medicina de la Universidad de Chile, Miguel O’Ryan, se refirió a la medida del gobierno de adelantar las vacaciones de invierno a los estudiantes ante el importante alza de enfermedades respiratorias en menores.